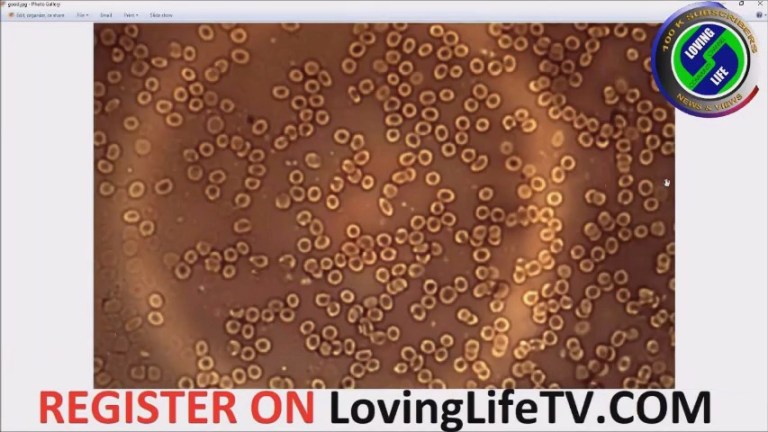

Source: The Expose (February 24, 2022)
By Rhoda Wilson
In his latest set of slides of blood samples taken from both “vaccinated” and unvaccinated people, Dr. Philippe van Welbergen demonstrated that the graphene being injected into people is organising and growing into larger fibres and structures, gaining magnetic properties or an electrical charge and the fibres are showing indications of more complex structures with striations.
He also demonstrated that “shards” of graphene are being transmitted from “vaccinated” to vaccine-free or unvaccinated people destroying their red blood cells and causing blood clots in the unvaccinated.
Dr. Philippe van Welbergen (“Dr. Philippe”), Medical Director of Biomedical Clinics, was one of the first to warn the public of the damage being caused to people’s blood by Covid injections by releasing images last year of blood samples under the microscope.
At the beginning of July 2021, Dr. Philippe, was interviewed on a South African community channel, Loving Life TV. He explained that when his patients started complaining about chronic fatigue, dizziness, memory issues, even sometimes paralysis and late onset of heavy menstruation (women in their 60s upwards), he took blood samples. Their blood had unusual tube-like structures, some particles which lit up and many damaged cells. Few healthy cells were visible. Until three months earlier, he had never seen these formations in blood. We now know these tube-like structures are graphene.
Since then, Dr. Philippe has been a regular guest on Loving Life TV: blowing the whistle on the experimental Covid injection roll-out; providing updates on the increasing damage being done to blood by the experimental Covid injections over time; and, giving updates on the Covid situation in the UK and South Africa.
On 12 February 2022, Dr. Philippe returned again to Loving Life TV to release images of his latest slides of blood samples. The live stream was lengthy so Loving Life TV separated it into two parts.
Part One is a discussion including answers to the audience’s questions.
In Part Two, Dr. Philippe presents the images of his latest blood slides and explains what the images are showing. He discusses nearly 100 blood slides from both “vaccinated” and vaccine-free patients. His slides show that vaccine-free patients have been “infected with vaccine toxins through shedding.”
Below is a short clip from Part Two courtesy of The Timeline Post channel on Telegram.
Below is an image of typical healthy red blood cells as seen with a microscope, what blood should look like. There is no coagulation or foreign objects in it.
The next image is of a person who has been injected with the experimental Covid drug. The blood is coagulated, the misshapen red blood cells are clumped together. The cell encircled in the image is a healthy red blood cell, one of the few in the image, sitting alongside the graphene fibres. You can see the size of the graphene fibres in relation to the size of a red blood cell. Fibres of this size will block capillaries. You can also see the graphene fibres are hollow and contain red blood cells.

The image below is of a blood sample from a vaccine-free, or unvaccinated, three-year-old child. It shows pieces or “shards” of graphene that “are the result of shedding,” in other words the graphene has been transmitted from “vaccinated” parents to their unvaccinated child.

The image below is of a blood sample from a vaccine-free, or unvaccinated, three-year-old child. It shows pieces or “shards” of graphene that “are the result of shedding,” in other words the graphene has been transmitted from “vaccinated” parents to their unvaccinated child.

Below is the image of a blood sample from an eight-year-old unvaccinated child whose blood has been contaminated and destroyed by the transmission of graphene from those around him/her who have had a Covid injection. The child’s right arm and upper right leg are basically paralysed, the child is unable to lift his/her right arm and the thigh is not functioning properly.

Dr. Philippe’s presentation is truly eye opening and horrifying – a must watch, especially for those who proclaim Covid injections are “safe” and are insisting people be injected. The Covid injections are weapons of genocide and how the people who have designed them are still walking free is incredible.
You can either watch the presentation below or on Loving Life TV HERE.
Source: The Expose
Follow The Expose here
Please see: Graphene Oxide The Vector For Covid-19 Democide
Also see: TRANSMISSION with Dr. Ariyana Love
